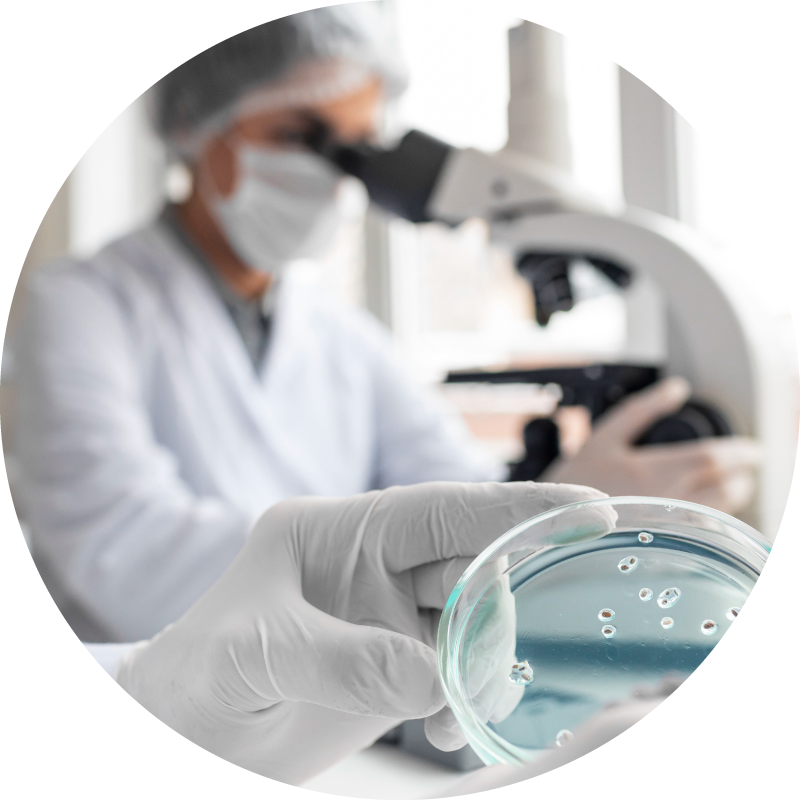
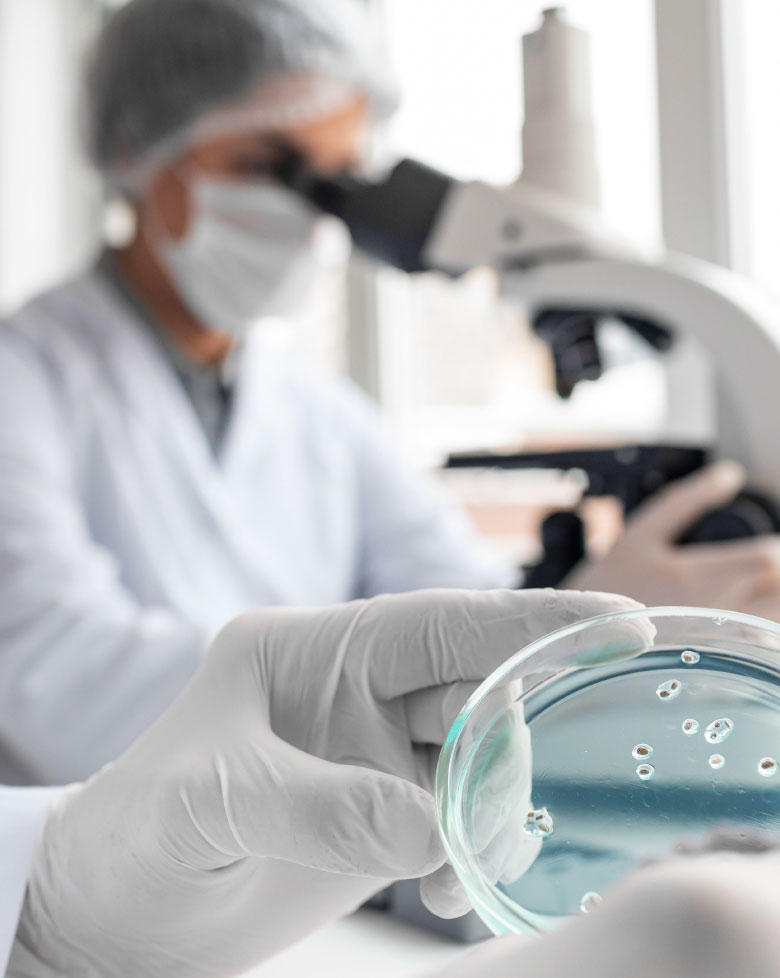

Microbiology Department
At the Microbiology Laboratory of Eurodiagnosi Corfu, the accuracy and reliability of our results are our top priority.
At the Microbiology Laboratory of Eurodiagnosi Corfu, the accuracy and reliability of our results are our top priority. With state-of-the-art equipment, strict quality protocols, and a team of specialized scientists and experienced healthcare professionals, we provide comprehensive diagnostic services that support accurate and timely diagnosis.
At the Microbiology Laboratory of Eurodiagnosi Corfu, we perform the full spectrum of laboratory tests, from routine analyses to fully specialized diagnostics, covering every patient need.
Our Services:
- Microbiological tests – Cultures of biological fluids
- Hematological tests
- Biochemical analyses
- Hormonal tests
- Immunological & Serological tests
- Toxicological tests
Molecular diagnostics (PCR & genetic testing), including:
-
Detection of respiratory viruses (COVID-19, RSV, Influenza)
-
Detection and typing of HPV-DNA
-
Thrombophilia screening
-
Cystic Fibrosis testing (CFTR)
-
HLA-B27 antigen detection
-
Detection of HBV & HCV
-
Expanding the range of its services, Eurodiagnosis Corfu Laboratory also offers specialized tests, such as the urea breath test for the diagnosis of Helicobacter pylori infection.

8th Side Street of Ioanni Theotoki, PC 491 32, Corfu.
Eurodiagnosis Corfu offers a range of initiatives and services aimed at promoting health and ensuring early diagnosis:
- Special check-up packages tailored for children and adults, covering both basic and specialized examinations.
- Special prices and offers on important global health awareness days, designed to raise awareness and make preventive screenings more accessible.
- Collaboration with the state’s “Prolavano” program, which provides free or subsidized preventive screenings for breast and cardiovascular diseases, as well as participation in any new public prevention initiatives introduced in the future.
Through these actions, Eurodiagnosis Corfu establishes a comprehensive framework for preventive care, contributing significantly to early diagnosis and effective treatment.










